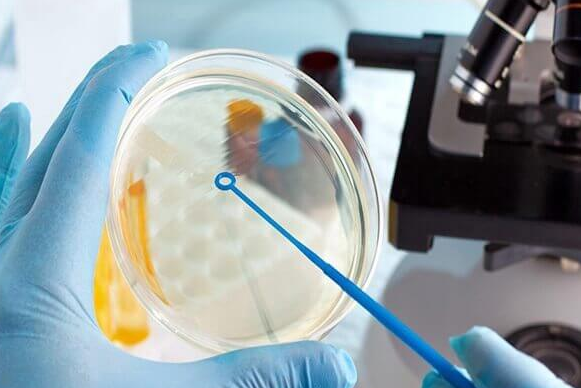

在生育难题困扰众多家庭的当下,杭州凭借其先进的试管婴儿技术,成为了许多夫妇实现生育梦想的希望之地。作为中国医疗资源高度集中的城市之一,杭州的试管婴儿技术已全面进入第三代(PGT)时代,为众多家庭带来了优生优育的新选择。
杭州的试管婴儿技术紧跟国际前沿,涵盖了第一代、第二代和第三代试管婴儿技术。第一代试管婴儿技术主要适用于女性输卵管堵塞、排卵障碍等问题;第二代则针对男性严重少弱精症等情况,通过显微操作技术将单个精子直接注射到卵子内;而第三代试管婴儿技术更为先进,它能在胚胎移植前对胚胎进行遗传学诊断和筛查,有效避免遗传性疾病的传递,降低流产风险。
在杭州,多家公立医院和私立机构在试管婴儿领域表现出色。例如,浙江大学医学院附属妇产科医院、邵逸夫医院等,不仅拥有国家卫健委批准的全牌照资质,还配备了国际领先的基因测序设备和时差培养系统,确保了检测结果的准确性和胚胎的高质量培养。这些医院的三代试管婴儿成功率普遍较高,部分优质生殖中心的成功率甚至达到了70%以上。
除了技术实力,杭州的试管婴儿服务也备受赞誉。从术前检查、促排卵监测到胚胎移植、孕期保健,全程由专业团队跟踪管理,减少了患者往返医院的次数。同时,医院还配备了专职心理咨询师,帮助患者缓解焦虑情绪,提供全方位的心理支持。
值得一提的是,自2025年起,杭州已将试管婴儿费用纳入医保报销范围,为不孕不育家庭带来了实质性的经济支持。这一政策的实施,使得更多家庭能够承担得起试管婴儿的费用,进一步推动了试管婴儿技术的普及和应用。







